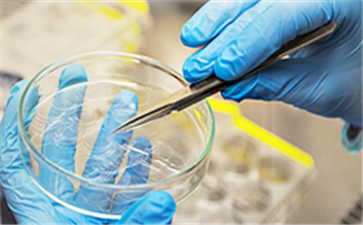

靶向药百科
*以上解读内容仅供参考,癌症123不对解读内容负责。
紫杉醇(安素泰)只能静脉输注给药!!
2018-04-19 据悉,紫杉醇(安素泰)在临床上与铂制剂联合应用治疗卵巢癌、常规治疗失败后的转移性乳腺癌的治疗、非小细胞肺癌(NSCLC)、与阿霉素、环磷酰胺联合治疗结节阳性乳腺癌。其
紫杉醇(安素泰)有哪些抗癌效果呢?
2018-04-19 据悉,紫杉醇(安素泰)在临床上常常用于卵巢癌、食管癌、淋巴瘤、乳腺癌等妇科疾病的治疗。那么在临床上可用于多种癌症的紫杉醇(安素泰)到底有哪些抗癌效果呢?
紫杉
紫杉
九个靶点的抗癌靶向药,全球只有卡博替尼XL184
2018-04-19卡博替尼,更多的人称他为XL184,简称184,卡博替尼的治疗靶点包括MET、VEGFR1、VEGFR2、VEGFR3、ROS1、RET、AXL、NTRK、KIT共九个靶点,是目前全球为一个拥有九个靶点的靶向
卡博替尼XL184对骨转移癌症患者有奇效
2018-04-19卡博替尼江湖人称184,是对各种癌症都能起到作用的神药,在治疗的过程中,研究人员发现,大部分的患者都是发生了骨转移,而使用卡博替尼XL184对骨转移得到而来控制,有奇效。
比卡鲁胺副作用处理方法,赶紧收藏吧!
2018-04-19药物的副作用我们不可避免,比卡鲁胺片的不良反应包括面色潮红、搔痒、另外乳房触痛和男性乳房女性化,它可随睾丸切除术减轻。
比卡鲁胺片也可能引起腹泻、恶心、呕吐和
比卡鲁胺长期服用会怎么样?
2018-04-19比卡鲁胺片是长效的口服非甾体类抗雄激素药物,与促黄体生成素释放激素(LHRH)类似物或外科睾丸切除术联合应用于晚期前列腺癌的治疗。是当今前列腺癌治疗药物中应用最广
爱必妥PK安维汀,肠癌患者该选择那个?
2018-04-19肠癌是目前比较常见的一种癌症,在治疗的过程中,一般都是手术化疗和放疗再就是靶向药治疗, 爱必妥与安维汀都是治疗肠癌的靶向治疗药物,对这两种药物,肠癌患者该选择那个?
爱必妥(西妥昔单抗)治疗大肠癌需要几个疗程?
2018-04-19在大肠癌的治疗过程中,最常使用的靶向药就是爱必妥,无论是单药治疗还是在与伊立替康联合使用,都能够起到非常好的疗效,对于爱必妥的使用,需要一定的疗程,才能发挥疗效,那爱必
靶向药爱必妥(西妥昔单抗)对晚期大肠癌效果好吗?
2018-04-19肠癌早期可以通过手术的方式治疗,到了晚期就已经不适合手术方式,治愈率也比较低,一般晚期都是以化疗为主,那靶向药爱必妥(西妥昔单抗)对晚期大肠癌效果好吗?
爱必妥
阿帕替尼(艾坦)能治疗小细胞肺癌吗?
2018-04-19众所周知,在晚期胃癌的治疗过程中,阿帕替尼(艾坦)是唯一的口服靶向药,在晚期胃癌标准化疗失败后的最佳选择,那阿帕替尼(艾坦)能治疗小细胞肺癌吗?
肺癌中的非小型细
阿帕替尼(艾坦)都可以治疗哪些癌症?
2018-04-19艾坦又叫做阿帕替尼,通用名是甲磺酸阿帕替尼片,主要是用在晚期胃癌的治疗,见效快,副作用少,深得患者们青睐。除了胃癌之外,阿帕替尼(艾坦)也用来治疗其他的癌症,具体是什么呢?
晚期胃癌吃阿帕替尼(艾坦)效果好吗?
2018-04-19统计显示,在去年发病的95万胃癌中,中国占据了差不多一半,是肺癌之后,第二大肿瘤,死亡率也是非常高,大部分的患者在检查出来的时候基本上已经是晚期,治疗手段有限,那晚期胃癌吃
阿比特龙失效可用恩杂鲁胺吗?
2018-04-19靶向治疗已经为很多肿瘤患者带来新生的希望。关于耐药,目前我们还没有很好的办法控制耐药的发生,不过医学研究者并没有坐以待毙,而是不断的发现耐药机制和研发新药,希望在
拉帕替尼:HER-2阳性早期乳腺癌新选择
2018-04-19拉帕替尼由葛兰素史克生的一种小分子表皮生长因子酪氨酸激酶抑制剂。主要用于联合卡培他滨治疗ErbB-2过度表达的,既往接受过包括蒽环类,紫杉醇,曲妥珠单抗(赫赛汀)治疗
紫杉醇(安素泰)副作用多吗?
2018-04-19 对于癌症患者来说,所使用的药品是否有副作用,副作用严不严重是非常重要的。那么紫杉醇(安素泰)作为多种癌症的“隐形杀手”副作用多吗?
紫杉醇(安素泰)副
紫杉醇(安素泰)副
红豆杉(紫杉醇)泡水能防癌?
2018-04-19 据说,很多网上流传红豆杉中提取的“紫杉醇”对多种晚期癌症疗效特殊,用用红豆杉的茎叶泡水可以防癌。
专家表示,紫杉醇能抗癌的说法不假,但红豆杉所含的&ld
专家表示,紫杉醇能抗癌的说法不假,但红豆杉所含的&ld
雷莫芦单抗(Cyramza)会导致女性患者不孕不育?
2018-04-19 据悉,雷莫芦单抗(Cyramza)可用于胃癌、非小细胞肺癌、结直肠癌等多种癌症的治疗,在临床应用中有很多患者选择此药来治疗疾病。
但是雷莫芦单抗(Cyramza)在临床应用
但是雷莫芦单抗(Cyramza)在临床应用
你必须要知道的雷莫芦单抗(Cyramza)用药须知!
2018-04-19 在临床应用中,雷莫芦单抗(Cyramza)是一种注射液,需在专业人士指导下使用。同时患者在使用过程中必须了解其药品的副作用、用法用量及注意事项。为此小编为大家查找了一份
使用雷莫芦单抗(Cyramza)引起高血压怎么办?
2018-04-19 生活中很多人都有高血压,严重者一直在身边常备降压药。近年来,随着雷莫芦单抗(Cyramza)的知名度,很多癌症患者都选择此药品来治疗疾病。但是一些患者使用了此药品后,引起了
雷莫芦单抗(Cyramza)可调整剂量吗?
2018-04-19 对于癌症患者来说,当服用的药品严重的副作用时可进行调整药品剂量或停用此药来解决。但是也有一些药品是无法调整剂量的。那么当雷莫芦单抗(Cyramza)这种药品出现副作用反
警示:雷莫芦单抗(Cyramza)在癌症中的用法用量不同!
2018-04-19 每一种药品在上市时都有其特定的药品说明书,药品说明书中都会标注药品的用法用量。但是你一定注意不到,作为多种癌症的靶向药雷莫芦单抗(Cyramza)在多种癌症中的用法用量
雷莫芦单抗(Cyramza)适应症
2018-04-19 我们都知道雷莫芦单抗(Cyramza)可用于多种癌症的治疗。到底雷莫芦单抗(Cyramza)的适应症有哪些呢?一起来了解。
雷莫芦单抗(Cyramza)适应症:
1.胃癌:单独给药
雷莫芦单抗(Cyramza)适应症:
1.胃癌:单独给药
雷莫芦单抗(Cyramza)可以放冰箱里吗?
2018-04-19 刘先生是一名胃癌患者,在医生的推荐下使用雷莫芦单抗(Cyramza)来治疗疾病。刘先生了解到印度仿制雷莫芦单抗(Cyramza)药品价格比较便宜,就直接去印度权威医院药房购买了一
乳腺癌靶向药赫赛汀的不良反应有什么?
2018-04-19赫赛汀最常见的不良反应为发热、恶心、呕吐、输注反应、腹泻、感染、咳嗽加重、头痛、乏力、呼吸困难、皮疹、中性粒细胞减少症、贫血和肌痛;需要治疗或停止赫赛汀治疗
赫赛汀也用于治疗胃癌?
2018-04-19胃癌高居各类癌症死因的第二位,每年新发病例约有40万人,由于早期胃癌患者没有临床症状,确诊的胃癌患者以中期或者晚期居多,很难通过手术完全治愈。近几年来,随着环境、饮食